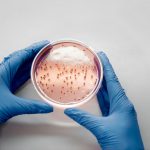

Corporación Para La Investigación En Salud Tropical – CORPOTROPICA
At Corpotrópica, we apply the One Health concept to combine science, innovation and community action to study, prevent, diagnose and control infectious diseases including emerging and vector-borne diseases in the Orinoco and Colombian Amazon. Our mission is to generate high-impact knowledge that lead to effective solutions to improve public health and the well-being of communities.
Join us in the fight against tropical diseases and be part of the change.
We lead research in public health to transform lives.

Since our foundation in 2010, we have established ourselves as a research center for infectious diseases conducting epidemiological and entomological surveillance, diagnosis and control of tropical diseases, including vector-borne diseases and zoonoses, under the One Health approach.
Our multidisciplinary team of experts in public health, veterinary medicine, biology, entomology and biotechnology leads applied research projects, specialized consultancies and prevention programs that contribute to the well-being of the most vulnerable communities.
Through strategic partnership with universities, government entities and international organizations, we promote innovative solutions to face the challenges of emerging and re-emerging diseases. At Corpotrópica, we believe that science and collaboration are the key tools to transform public health.
Our mission is clear: research, innovate and act for a healthier future.


We conduct rigorous research and scientific studies to deepen our understanding of infectious diseases and develop effective strategies for their control. Our work focuses on emerging and vector-borne diseases with significant public health impact. Through interdisciplinary collaboration and knowledge generation, we aim to advance scientific understanding, inform policy decisions, and contribute to the development of evidence-based interventions that protect and improve community health.
We offer advising and training on diagnostic laboratory methods as well as provide services for identification, prevention, and control of infectious diseases. Our approach integrates advanced tools in molecular biology and genomics, including PCR, next-generation sequencing, and bioinformatics analysis, to enhance pathogen detection, surveillance, and epidemiological studies. By leveraging these cutting-edge technologies, we support research and diagnostics that contribute to a deeper understanding of infectious diseases and the development of effective strategies for their management and control.
We focus on developing innovative technologies for the study, prevention, and control of infectious diseases, enhancing public health through cutting-edge research, advanced diagnostics, and data-driven solutions. By integrating molecular biology, genomics, and bioinformatics, we aim to improve disease surveillance, early detection, and intervention strategies, ultimately reducing the impact of infectious diseases on communities worldwide.
Through hands-on training, mentorship, and innovative learning approaches, we equip future experts with the skills and knowledge necessary to address emerging challenges in their fields. Our programs foster critical thinking, technical expertise, and a commitment to scientific excellence, ensuring that the next generation of professionals is prepared to drive innovation, advance research, and contribute to sustainable solutions in their communities.
Over the years, Corpotrópica has participated on various interinstitutional research projects that have resulted in notable scientific publications. Below are some of these:
The study investigated the Lutzomyia antunesi, a vector species of cutaneous leishmaniasis, which is endemic in the Orinoquía region of Colombia. For one year, seasonal variation and natural infection of this vector was studied. Specimens of insects were captured in different housing areas using light traps. Natural infection with Leishmania spp was detected in several species, with L. antunesi showing a 1% infection rate. Furthermore, the seasonal analysis revealed that the abundance of L. antunesi increased in the warmest months, correlating with maximum temperatures and low precipitation. More info visit: https://pubmed.ncbi.nlm.nih.gov/23828011/


